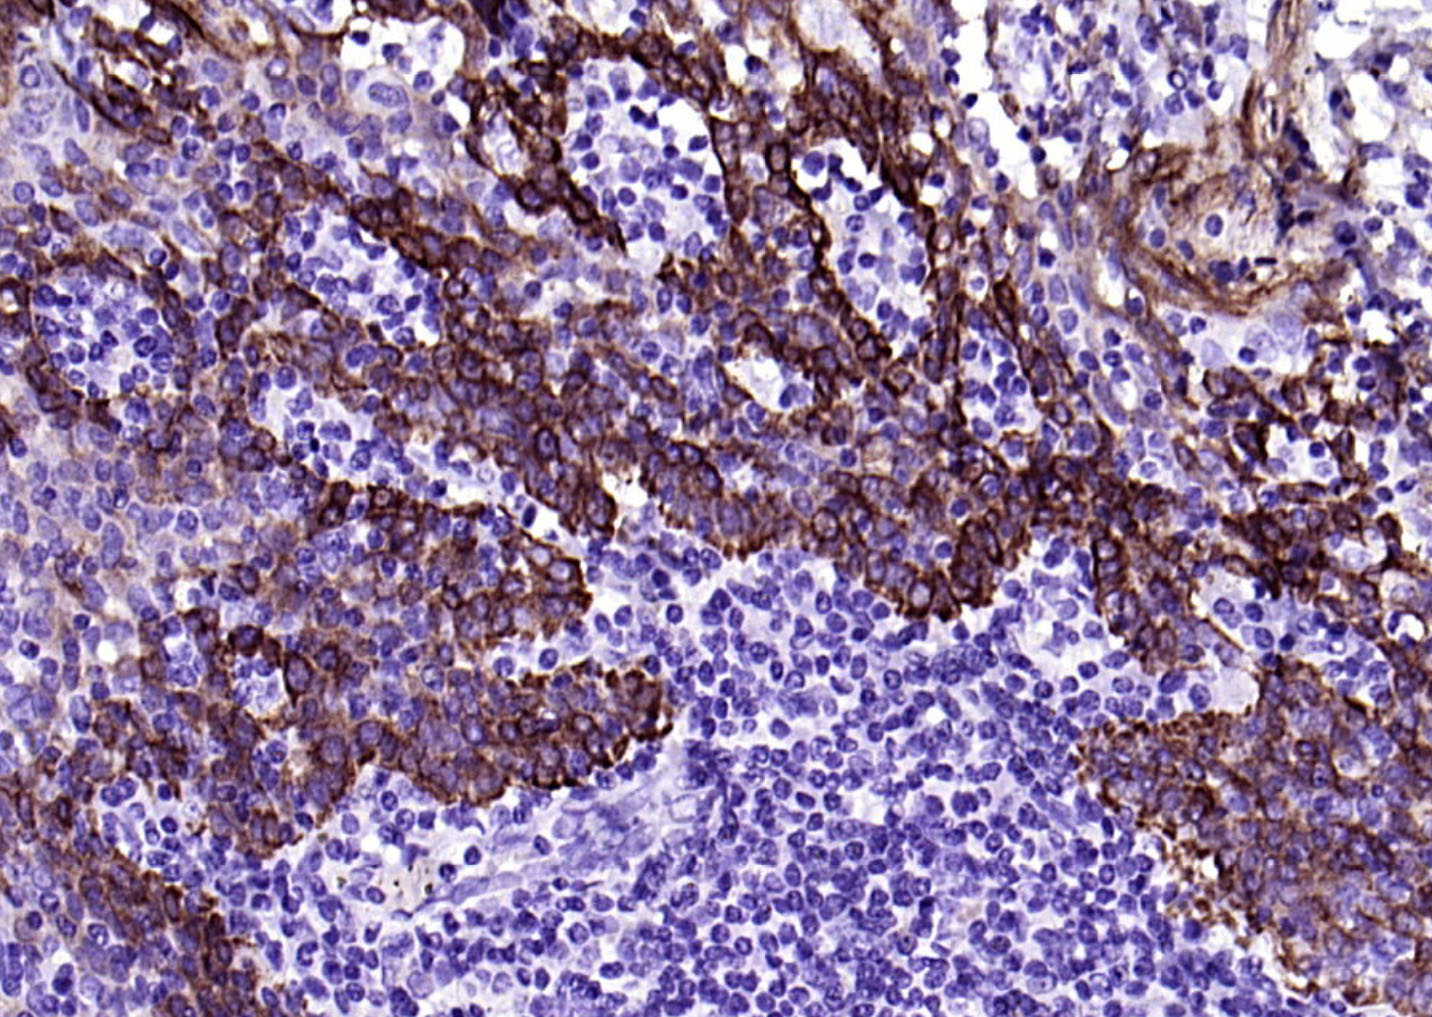
细胞角蛋白17单克隆抗体-bsm-33087M

CK17 Mouse mAb (一抗) - WB,IHC-P,IHC-F,IF | Bioss

货号:bsm-33087M
产品详情
相关标记
相关产品
相关文献
常见问题
概述
产品编号
bsm-33087M
产品类型
病理级抗体
英文名称
CK17 Mouse mAb
中文名称
细胞角蛋白17单克隆抗体
英文别名
39.1; CK-17; K17; PC; PC2; PCHC1; Krt1-17; Ka17; K1C17_HUMAN; KRT17; Cytokeratin-17 (CK-17); Keratin-17 (K17); K1C17_MOUSE; K1C17_RAT; Type I keratin Ka17;
抗体来源
Mouse
免疫原
KLH conjugated synthetic peptide derived from human CK17
亚型
IgG
性状
Size : 50ul/100ul/200ul
Liquid
Size : 200ug (PBS only)
Lyophilized
Note: Centrifuge tubes before opening. Reconstitute the lyophilized product in distilled water. Optimal concentration should be determined by the end user.
Liquid
Size : 200ug (PBS only)
Lyophilized
Note: Centrifuge tubes before opening. Reconstitute the lyophilized product in distilled water. Optimal concentration should be determined by the end user.
纯化方法
affinity purified by Protein G
克隆类型
Monoclonal
克隆号
12B1
理论分子量
47 kDa
检测分子量
46 kDa
浓度
1mg/ml
储存液
Size : 50ul/100ul/200ul
0.01M TBS (pH7.4) with 1% BSA, 0.02% Proclin300 and 50% Glycerol.
Size : 200ug (PBS only)
0.01M PBS
0.01M TBS (pH7.4) with 1% BSA, 0.02% Proclin300 and 50% Glycerol.
Size : 200ug (PBS only)
0.01M PBS
研究领域
SWISS
Gene ID
保存条件
Shipped at 4℃. Store at -20℃ for one year. Avoid repeated freeze/thaw cycles.
注意事项
This product as supplied is intended for research use only, not for use in human, therapeutic or diagnostic applications.
数据库链接
产品介绍
结构蛋白(Structural Proteins)
常用于肿瘤细胞的分化、增殖及转移方面的研究。
常用于肿瘤细胞的分化、增殖及转移方面的研究。
背景资料
The protein encoded by this gene is a member of the keratin family. The keratins are intermediate filament proteins responsible for the structural integrity of epithelial cells and are subdivided into cytokeratins and hair keratins. The type I cytokeratins consist of acidic proteins which are arranged in pairs of heterotypic keratin chains. Unlike its related family members, this smallest known acidic cytokeratin is not paired with a basic cytokeratin in epithelial cells. It is specifically expressed in the periderm, the transiently superficial layer that envelopes the developing epidermis. The type I cytokeratins are clustered in a region of chromosome 17q12-q21.
This gene encodes the type I intermediate filament chain keratin 17, expressed in nail bed, hair follicle, sebaceous glands, and other epidermal appendages. Mutations in this gene lead to Jackson-Lawler type pachyonychia congenita and steatocystoma multiplex. [provided by RefSeq, Aug 2008].

产品应用
| 应用 | 已检合格种属 | 预测种属 | 推荐稀释比例 |
|---|---|---|---|
| WB | Human | 1:500-1000 | |
| IHC-P | Human | 1:100-500 | |
| IHC-F | Human | 1:100-500 | |
| IF | Human | 1:100-500 |
交叉反应
交叉反应: Human
相关产品
暂无相关产品
靶标
基因名
KRT17
蛋白名
Keratin, type I cytoskeletal 17
亚基
Heterodimer of a type I and a type II keratin. KRT17 associates with KRT6 isomers. Interacts with TRADD and SFN.
亚细胞定位
Cytoplasm.
组织特异性
Expressed in the outer root sheath and medulla region of hair follicle specifically from eyebrow and beard, digital pulp, nail matrix and nail bed epithelium, mucosal stratified squamous epithelia and in basal cells of oral epithelium, palmoplantar epidermis and sweat and mammary glands. Also expressed in myoepithelium of prostate, basal layer of urinary bladder, cambial cells of sebaceous gland and in exocervix (at protein level).
疾病
Defects in KRT17 are a cause of pachyonychia congenital type 2 (PC2) [MIM:167210]; also known as pachyonychia congenital Jackson-Lawler type. PC2 is an autosomal dominant ectodermal dysplasia characterized by hypertrophic nail dystrophy resulting in onchyogryposis (thickening and increase in curvature of the nail), palmoplantar keratoderma and hyperhidrosis, follicular hyperkeratosis, multiple epidermal cysts, absent/sparse eyebrow and body hair, and by the presence of natal teeth.
Defects in KRT17 are a cause of steatocystoma multiplex (SM) [MIM:184500]. SM is a disease characterized by round or oval cystic tumors widely distributed on the back, anterior trunk, arms, scrotum, and thighs.
Note=KRT16 and KRT17 are coexpressed only in pathological situations such as metaplasias and carcinomas of the uterine cervix and in psoriasis vulgaris.
Defects in KRT17 are a cause of steatocystoma multiplex (SM) [MIM:184500]. SM is a disease characterized by round or oval cystic tumors widely distributed on the back, anterior trunk, arms, scrotum, and thighs.
Note=KRT16 and KRT17 are coexpressed only in pathological situations such as metaplasias and carcinomas of the uterine cervix and in psoriasis vulgaris.
相似性
Belongs to the intermediate filament family.
功能
May play a role in the formation and maintenance of various skin appendages, specifically in determining shape and orientation of hair. May be a marker of basal cell differentiation in complex epithelia and therefore indicative of a certain type of epithelial 'stem cells'. May act as an autoantigen in the immunopathogenesis of psoriasis, with certain peptide regions being a major target for autoreactive T-cells and hence causing their proliferation. Required for the correct growth of hair follicles, in particular for the persistence of the anagen (growth) state. Modulates the function of TNF-alpha in the specific context of hair cycling. Regulates protein synthesis and epithelial cell growth through binding to the adapter protein SFN and by stimulating Akt/mTOR pathway. Involved in tissue repai.
同靶标产品
相关文献
提示: 发表研究结果有使用 bsm-33087M 时请让我们知道,以便我们可以引用参考文章。作为回馈,资料提供者将获得我们送上的小礼品。